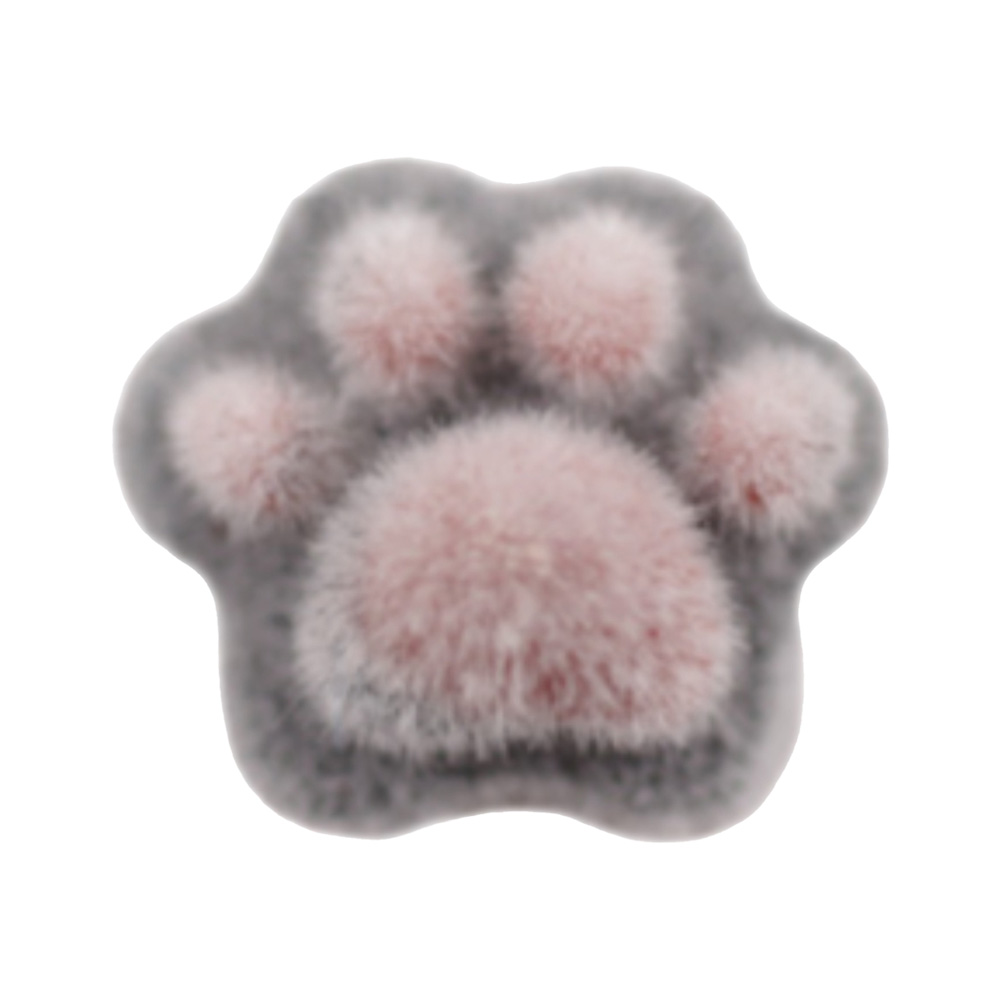
マティエール ふわもこ肉球 1.0×1.0mm ブラック 4P 4064

- HOME
- マティエール ふわもこ肉球 1.0×1.0mm ブラック 4P 4064
 ログイン
ログイン
 まとめてオーダー
まとめてオーダー
カタログコード一括注文 ブランドから探す
ブランドから探す
ブランド一覧へ カテゴリーから探す
カテゴリーから探す
- 新商品
- CHRISTRIO
- Palms Graceful
- POSH ART
- NYCOGEL
- 25GEL
- ジェル
- アクリリック
- ブラシ
- チップ
- ポリッシュ
- ケア
- ファイル
- ニッパー・ツール類
- アート
- 衛生管理用品
- 備品・器具
- マシン
- エアブラシ
- テーブル・チェア他
- ネイリスト検定
- 書籍・雑誌
- アイラッシュ
- 美容・その他
- キャンペーン/アウトレット
- HP未掲載商品ご注文時
- ブランド別
- 割引対象外
- ▼15
- NES(エヌイーエス)
- CHRISTRIO(クリストリオ)
- Palms Graceful(パームスグレイスフル)
- vibrant by Palms Graceful(ビブラント)
- NYCOGEL(ニコジェル)
- 25GEL(ニーゴージェル)
- POSH ART(ポッシュアート)
- ageha(アゲハ)
- AIRTEX(エアテックス)
- AKZENTZ(アクセンツ)
- ALEANA HAND(アリアナハンド)
- AMO'COSME(アモズコスメ)
- amut.(アミュット)
- ANCLEF(アンクレ)
- AirGel(エアジェル)
- Ann professional(アンプロフェッショナル)
- and graph(アンドグラフ)
- AROMAS(アロマス)
- atelier NOVEL(ノベル)
- ARTIS di Voce(アーティスディヴォーチェ)
- AURORA(オーロラ)
- Barbie(バービー)
- BANDI(バンディ)
- b-r-s(ブルーシュ)
- Baby Mirage(ベビーミラージュ)
- Backscratchers(バックスクラッチャーズ)
- Beauty Craft(ビューティークラフト)
- BEAUTY NAILER(ビューティーネイラー)
- Bellaforma(ベラフォーマ)
- Bio sclupture Gel(バイオスカルプチュアジェル)
- BJC(ビージェーシー)
- BL(ブリンクラッシュ)
- BLC for Corde(ビーエルシーフォーコーデ)
- BLUE CROSS(ブルークロス)
- Bonnail(ボンネイル)
- Boutique Korea(ブティックコリア)
- C.O.R.E.GEL(コアジェル)
- Can I(キャンアイ)
- Charlon(シャルロン)
- Chelsea(チェルシー)
- CindiBendi(シンディベンディ・旧クレア)
- CND(シ-エヌディー)
- DLAW(ドロー)
- DIAMI(ダイアミ)
- D.nail(ディーネイル)
- Dna Gel(ディーナジェル)
- emena(エメナ)
- etoile(アイエトワール)
- eriko nail(エリコネイル)
- Fantasy Nails(ファンタジーネイルズ)
- FiFTY ViSiONARY(フィフティ・ヴィジョナリー)
- fleurir(フルーリア)
- flicka nail arts(フリッカネイルアーツ)
- Flowery(フラワリー)
- Fueki(フエキ)
- GELIST(ジェリスト)
- GELGRAPH(ジェルグラフ)
- GRACE(グレース)
- HARMONY(ハーモニー)
- holbein(ホルベイン)
- ibd(アイビーディー)
- ICEGEL(アイスジェル)
- INITY(アイニティ)
- IGNY(イグニ―)
- Irie(アイリー)
- J-jel(ジェイジェル)
- JESSICA(ジェシカ)
- Jewelry jel(ジュエリージェル)
- JNA(ジェイエヌエー)
- KiraNail(キラネイル)
- KOKOIST(ココイスト)
- Krimth(クリムス)
- krisno(クリスノ)
- KT(コヤマトレーディング)
- LCN(エルシーエヌ)
- LEAFGEL(リーフジェル)
- lem.(レム)
- Little Pretty(リトルプリティー)
- LUCU GEL(ルクジェル)
- MATIERE(マティエール)
- Medicom(メディコム)
- Melty Gel(メルティジェル)
- MENDA(メンダ)
- Mirage(ミラージュ)
- Miss eye d'or(ミスアイドール)
- Miss Mirage(ミスミラージュ)
- Mithos(ミトス)
- MoreCouture(モアクチュール)
- M・GEL/Mpetit(エムジェル・エムプティ)
- moano(モアノ)
- my&bee(マイビー)
- m.Soin(エムドットソワン)
- MX Mirage(ムクスミラージュ)
- NAIL DE DANCE(ネイルデダンス)
- Nail garden(ネイルガーデン)
- Nail Labo(ネイルラボ)
- Nail’s Magic(ネイルズマジック)
- Nakasone(ナカソネ)
- NFS(ナチュラルフィールドサプライ)
- noiro(ノイロ)
- `ohana×DWME(オハナ×デイダブルミイ)
- OPI(オーピーアイ)
- oui nails(ウィネイルズ)
- カラーEX
- P・Shine(ピーシャイン)
- para gel(パラジェル)
- PREANFA(プリアンファ)
- PREANFA(プリアンファ・アイラッシュ)
- PREGEL(プリジェル)
- PRECIOSA(プレシオサ)
- PRESTO(プレスト)
- Pretty Nail(プリティーネイル)
- RESISTANCE PLATE(レジスタンスプレート)
- rieugel(リュージェル)
- ROORO(ローロ)
- sacra(サクラ)
- SARURU(サルル企画)
- Sazalea(サザレア)
- scena(シーナ)
- SERUM’S(セラムズ)
- SHAREYDVA(シャレドワ)
- SHINYGEL(シャイニージェル)
- SMint(エスミント)
- soaddicted(ソーアディクティッド)
- SPACE CAST(スペースキャスト)
- SPACE NAIL(スペースネイル)
- SPALITUAL(スパリチュアル)
- SpaLuce(スパルーチェ)
- SPICARE(スピケア)
- Sunshine Babe(サンシャインベビー)
- SUWADA(スワダ)
- Tammy Toylar(タミーテイラー)
- Toolworx(ツールワークス)
- TOY's × INITY(トイズ×アイニティ)
- TSUMEKIRA(ツメキラ)
- URAWA(ウラワ)
- VETRO Bellanail LABEL(ベラネイル)
- VETRO mikinail(ミキネイル)
- VETRO(ベトロ)
- WSPT JAPAN(ダブリューエスピーティージャパン)
- スーパーネイル
- タカラベルモント
- ピカエース
- マルト長谷川(マルトハセガワ)
- 光(ヒカリ)
- 写ネイル(シャネイル)
- 内海(ウツミ)
- 革職人SUD NUVOLA(スドゥヌーボラ)
- その他ブランド

ご注意事項
・印刷物やPCの環境等によって、色味が現物と異なる場合がございますが、その際は現物を優先させていただきます。